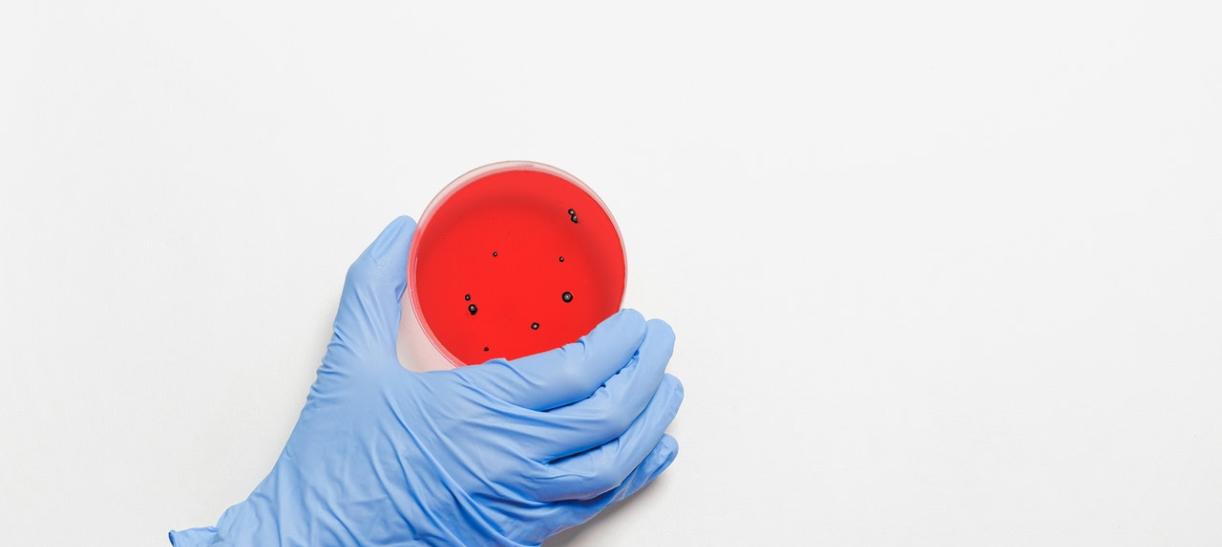

Así se están conteniendo los casos de viruela símica en Colombia
La Organización Mundial de la Salud (OMS), declaró la viruela símica como una emergencia de salud pública internacional.
Fernando Ruiz Gómez, ministro de Salud y Protección Social, explicó que la viruela símica es una enfermedad que hace más de 50 años está circulando en África, y recientemente, comenzó a presentarse en Europa y el continente americano.
Además, explicó el trabajo que realiza Colombia e indicó que se hace vigilancia intensiva para identificar posibles casos.
Ruiz Gómez destacó que es una enfermedad que se ha caracterizado en esta última aparición por su baja letalidad, por debajo del 0,03 %y es una enfermedad relativamente de bajo contagio, si uno la compara con el covid19, por ejemplo.
“Esta es de menor contagio y de menor severidad, por lo tanto, no representa una amenaza de la dimensión del Covid-19, pero existe evidencia de que en varios países de Europa hay transmisión comunitaria, así como en los Estados Unidos, Brasil y en Perú”, agregó.
En cuanto a Colombia, el jefe de la cartera de Salud resaltó que hasta el momento se tiene confirmación de 11 casos, de los cuales 10 tuvieron origen fuera del país. “De manera que en este momento nos encontramos en una fase de contención, lo cual representa una oportunidad muy importante para el país”, agregó el funcionario.
Asimismo, el ministro señaló que, desde el 30 de mayo pasado, junto al Instituto Nacional de Salud (INS), la cartera de Salud inició la fase de vigilancia intensificada, con seguimiento de casos a nivel nacional.
“En este momento tenemos una red de diagnóstico ya bastante amplia habilitada, el diagnóstico de la enfermedad se hace por biología molecular (prueba PCR) y esa misma red puede soportar el diagnóstico”, precisó el ministro.
No obstante, ya está habilitado el laboratorio central del INS, cinco laboratorios departamentales de salud pública, y 12 laboratorios, tanto de la red de biología molecular, como de la red genómica, de manera que los colombianos pueden estar tranquilos “porque hay capacidad suficiente para realizar el diagnóstico”.
Por otra parte, se dieron las instrucciones a nivel nacional para la contención de la enfermedad y con Migración Colombia, se tiene establecido el protocolo de ingreso al país, que permita identificar las personas que puedan tener la enfermedad, con el fin de hacer aislamiento lo más pronto posible.
“El aislamiento de la enfermedad se estima en alrededor de 21 días, en el caso de que se tenga la enfermedad, que es la fase en la cual puede haber mayor riesgo de contagio”, detalló Ruiz Gómez.
El ministro, por otra parte, destacó que en este momento se está entregando a las EPS del país los lineamientos para que, dentro de su red de atención, se designe al menos un centro de referencia para la atención de las personas con esta enfermedad, con el fin de hacer más efectivo el diagnóstico y tener capacidad rápida de detección de las personas contagiadas.
Entre otros aspectos, el ministro Ruiz Gómez hizo un “llamado a la tranquilidad”, teniendo en cuenta que, hasta el momento, este no es un fenómeno de las dimensiones del Covid.
“No tiene una transmisión tan acelerada, no tiene una mortalidad elevada. Es una enfermedad que obviamente genera molestias, que es contagiosa, pero indudablemente el llamado es a mantener una situación de tranquilidad y confiar en los servicios de salud, el sistema de salud y sus EPS”, aseguró.
Por último, el ministro destacó que las mismas medidas para el coronavirus funcionan: lavado de manos y distanciamiento, “estas son medidas que todos podemos trabajar para prevenir”.
REDACCIÓN CANAL INSTITUCIONAL